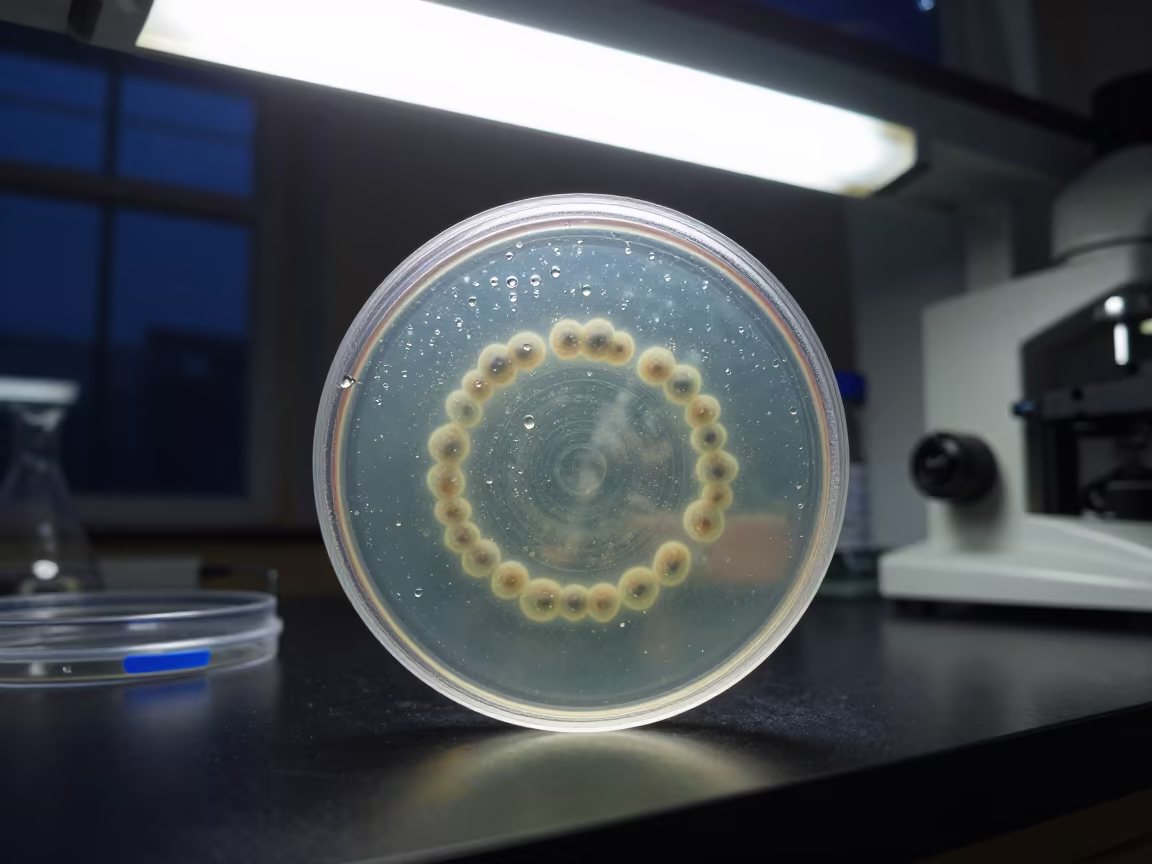
Lab Colony Ringed by Condensation Under Fluorescent Light in at an engineering workbench in Hillah

Silver Droplets on Reflux Column Midnight Lab
Stark fluorescent light floods a glass reflux column standing vertically in the center of a university research laboratory near Rotorua. Hundreds of silver droplets bead along the vertical ridges of the glass, catching the overhead glow in sharp, linear reflections. The column rests on a stainless steel ring stand, its metallic sheen mirroring the fixtures above. Behind the apparatus, white tiled walls and a row of dark safety cabinets define the space. The midsummer night outside remains sealed away, leaving only the sterile environment visible. A faint reflection of the silver beads stretches across the polished countertop, ending abruptly at the edge of the glass base.
<a href="https://img.veeter.com/silver-droplets-reflux-column-midnight-lab"><img src="https://cdn.veeter.com/img/silver-droplets-reflux-column-midnight-lab" alt="Silver Droplets on Reflux Column Midnight Lab in inside a university research lab near Rotorua"></a>
Free to download. CDN hosting requires a link back to this page. Terms
Similar Images

Silver Droplets on Reflux Column in Tianjin Lab
Sony a9 II · in a fossil prep lab in Tianjin

Pearlescent Flask Swirling in Tokyo Lab Midnight
Canon EOS 800D · inside a clean room near Tokyo

Amber Separatory Funnel in Pereira Lab Twilight
Canon EOS-1D X Mark III · inside a university research lab in Pereira

Pearlescent Flask in Elche Science Lab
Canon EOS 300D · in a bright laboratory near Elche

Swirling Flask in Bangalore Archive Lab
Fujifilm X-T5 · in a specimen archive room in Bangalore

Flask Swirling in Observatory Lab
Sony a7C II · inside an observatory control room near Tabou
Lab Colony Ringed by Condensation Under Fluorescent Light
Nikon FM3A · at an engineering workbench in Hillah

Red-Lit Flask Swirls in Yokohama Archive
Google Pixel 7 · in a specimen archive room in Yokohama

Midnight Freezer Room Projector Glow Near Solapur
Leica M-A · in a bright laboratory near Solapur

Amber Vials in Laboratory Twilight
iPhone 16 Plus · inside a clean room near Benin City

Amber Liquid Funnel in Belem Archive
Zorki 4 · in a specimen archive room near Belem

Green Chemistry Glow in Qingdao Lab at Twilight
Ricoh GR III · in Qingdao

Amber Separatory Funnel in Conakry Lab
Panasonic Lumix DC-S1 · in a bright laboratory in Conakry

Green Chemistry Glow in Lausanne Sunset
Google Pixel 7 · in Lausanne

Midnight Lab Bench with Flasks and Notes
Sony a6600 · inside a university research lab in Hoi An

Midnight Lab Rack with Stained Slides Santa Fe
Sony a7C · beside a tidal survey transect in Santa Fe

Amber Vials in Winter Lab Rotorua
Canon EOS R8 · inside a clean room in Rotorua

Midnight School Lab With Stools And Water Bottles
Minolta Maxxum 7000 AF · in a school laboratory near Ningbo

Kaleidoscope Mirrors in Ipoh Atrium at Midnight
Google Pixel 6 · inside a vaulted atrium in Ipoh

Upside-Down Lab Reflection in Water Ceiling
Nikon F3 · inside a university research lab near Taichung

Twilight Science Lab Bench with Glassware and Notes
Mamiya RB67 · in a bright laboratory in Fuzhou

Glowing Flask on Ledge in Lusaka Blue Hour
Leica Q3 · on a painted display ledge in Lusaka

Amber Liquid in Separatory Funnel at Hefei Lab
Leica IIIb · at an engineering workbench in Hefei

Glowing Green LEDs on Science Lab Shelf
Samsung Galaxy S21 · in Warnes

Serum Tubes in Observatory Lab
Sony a6400 · inside an observatory control room near Lakota

Sterile Sink Row in Finnish Hospital Before Dusk
Leica II · at a nurse station under monitor glow in Oulu

Night Prep in Nagoya Retail Aisle
Nikon D750 · inside a bright retail aisle near Nagoya

Upward Rain Streaks in Kota Kinabalu Medical Fridge
Huawei Mate 60 Pro · inside an imaging suite near Kota Kinabalu

Specimen Fridge Sky Day Night Zurich
Nikon D500 · inside a clinic exam room near Zurich

Pearlescent Flask Swirling in Archive Lab
Zorki 10 · in a specimen archive room near Victoria Seychelles

Redwood Cathedral Altar Night Fluorescent Light
Canon AE-1 · at the foot of a stone altar in Chiba

Red-lit Lab Cover Slip Box with Frozen Water Splash
Canon EOS 550D · inside a university research lab in Hangzhou

Nighttime Surgical Scrub Sink Row Clinic Barranquilla
Canon EOS R7 · inside a clinic exam room in Barranquilla

Condensation on Convenience Store Fridge Door Midnight
Kiev 5 rangefinder · inside a storefront prepared for opening near Kot Addu

Sterile Medical Shelf in Ankara Clinic Twilight
Canon EOS 300D · inside a clinic exam room in Ankara

Petri Dish Colony Ringed by Condensation in Lab Light
Zorki 5 · inside a university research lab near Kerman

Red-Lit Lab Centrifuge Tubes at Night in Medea
Pentax MX · at an engineering workbench in Médéa

Flask Swirling in Taipei Lab
Nikon F4 · at a microscopy bench near Taipei

Amber Liquid Separatory Funnel Science Lab
Canon EOS 5Ds · at a microscopy bench near Santos
Comments